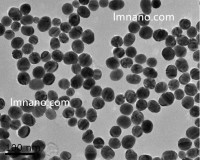
5nm-100nm 亲和素金纳米颗粒

万千商家帮你免费找货
0 人在求购买到急需产品
- 详细信息
- 文献和实验
- 技术资料
- 库存:
5000
- 英文名:
/
- CAS号:
/
- 保质期:
3年
- 供应商:
中科雷鸣(北京)科技有限公司
- 保存条件:
常温
- 规格:
1ml
聚苯乙烯荧光微球具有荧光强度高,性能稳定,粒径分布窄等特性, 可广泛用于医疗诊断、血流测定、示踪、体内成像,以及成像仪器和流式细胞仪的校准。 因为,我们的染料并非仅仅是结合在微球表面上,而是填充到微球内部,所以它们相对不易受光漂白作用和其他环境因子的影响,微球就算经过高速离心,也不会发生染料泄露。羧基化修饰的微珠表面有高密度的均匀分布的羧酸, 这使得它们适合于通过诸如碳化二亚胺(EDAC) 等水溶性的亚胺类试剂共价偶合蛋白质和其他含有胺基的生物分子。
荧光微球主要特点
• 进口荧光染料分子包埋在微球内部基质中集中发光,荧光信号更加稳定
• 可接受不同表面官能团以及不同规格大小的定制(50nm-100um)
• 填充了近10%的荧光染料,确保了荧光信号的高强度,高亮度
• 粒径高度均一(CV%小于5%),批间差小,重复性好
荧光微球技术参数
• 成分: 含有荧光染料聚苯乙烯 (Fluorescence Polystyrene)
• 密度: 1.05 g/cm3
• 折射指数: 1.59 @ 589 nm (25°C)
• 添加剂: 含有微量的表面活性剂
| 橙色荧光微球 |
||||
| 荧光色彩: |
高亮橙色荧光 |
|||
| 直径: |
50nm-100um |
|||
| 表面官能团: |
COOH |
|||
| 荧光光谱特性: |
激发波长:570nm,发射波长:610nm |
|||
| 保存条件: |
2-8度冷藏,避光 |
|||
| 包装规格 |
1ml,5ml,50ml |
|||
| 要求陈述: |
产品尺寸规格及表面官能团可定制 |
|||
| 货号 |
粒径 |
荧光 |
固含量 |
|
| PSOF00050 |
50nm |
橙色荧光 |
1% |
|
| PSOF00100 |
100nm |
橙色荧光 |
1% |
|
| PSOF00200 |
200nm |
橙色荧光 |
1% |
|
| PSOF00300 |
300nm |
橙色荧光 |
1% |
|
| PSOF00400 |
400nm |
橙色荧光 |
1% |
|
| PSOF00500 |
500nm |
橙色荧光 |
1% |
|
| PSOF00600 |
600nm |
橙色荧光 |
1% |
|
| PSOF00800 |
800nm |
橙色荧光 |
1% |
|
| PSOF01000 |
1um |
橙色荧光 |
1% |
|
| PSOF02000 |
2um |
橙色荧光 |
1% |
|
| PSOF03000 |
3um |
橙色荧光 |
1% |
|
| PSOF04000 |
4um |
橙色荧光 |
1% |
|
| PSOF05000 |
5um |
橙色荧光 |
1% |
|
| PSOF10000 |
10um |
橙色荧光 |
1% |
|
| PSOF15000 |
15um |
橙色荧光 |
1% |
|
| PSOF20000 |
20um |
橙色荧光 |
1% |
|
| PSOF30000 |
30um |
橙色荧光 |
1% |
|
| PSOF50000 |
50um |
橙色荧光 |
1% |
|
| PSOF100000 |
100um |
橙色荧光 |
1% |
|





风险提示:丁香通仅作为第三方平台,为商家信息发布提供平台空间。用户咨询产品时请注意保护个人信息及财产安全,合理判断,谨慎选购商品,商家和用户对交易行为负责。对于医疗器械类产品,请先查证核实企业经营资质和医疗器械产品注册证情况。
 文献和实验
文献和实验相关专题 荧光 微球分析技术属于化学材料发展结果,可用于细胞表面抗原的检测、退行性神经病变示踪物、吞噬功能的检测、血流分析、敏感性诊断试剂等,本文介绍了荧光微球分析技术以及荧光微球吞噬实验的操作步骤。 荧光微球分析 技术简介 荧光微球分析技术是近年来化学材料科学活跃发展 的产物,各种大小(0.2~10μm)可产生荧光和色彩的人工微球应运而生,目前各种材料人工合成、多种颜色和规格的荧光微球有2大类,一种
【共享】巨噬细胞吞噬荧光微球试验-Phagocytosis and Microparticles
最近接到流式细胞仪检测巨噬细胞吞噬荧光微球试验这么个活,既不熟悉流式也不熟悉吞噬细胞,彻底茫然状态。连该买哪种微球都搞不清,微球好贵又不敢乱试。苦找了很久在一些微球公司的网页找到一点自认很有用的文件,拿出来共享,希望与我遇到同样麻烦的同仁看了能有帮助。———————————————————部分引用——————————————————Synthetic polymeric particles have been used extensively to study phagocytosis
层析技术中,通常选择将特异性抗体或抗原固定在大孔径的微孔滤膜(NC膜)上,根据我们多家测试比对结果,推荐使用sartorius - CN140 的膜作为NC膜,但也需要根据实际项目需求调整NC膜类型。 02 样品垫及释放垫的材质和型号 不同材质或不同型号的样品垫和释放垫也会影响微球的释放。一般而言,针对彩色微球和时间分辨荧光微球推荐选用玻璃纤维材质的、亲水性的膜作为样品垫或结合垫。如下图两种不同型号释放垫的释放对比: 三 . 彩色微球和时间分辨荧光微球在免疫层析技术中的应用 为度生物可以提供连接了羧基
 技术资料
技术资料暂无技术资料 索取技术资料